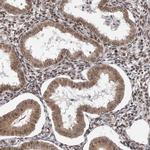
VPS37A Antibody in Immunohistochemistry (IHC)

Search
Invitrogen
VPS37A Polyclonal Antibody
{{$productOrderCtrl.translations['antibody.pdp.commerceCard.promotion.promotions']}}
{{$productOrderCtrl.translations['antibody.pdp.commerceCard.promotion.viewpromo']}}
{{$productOrderCtrl.translations['antibody.pdp.commerceCard.promotion.promocode']}}: {{promo.promoCode}} {{promo.promoTitle}} {{promo.promoDescription}}. {{$productOrderCtrl.translations['antibody.pdp.commerceCard.promotion.learnmore']}}
产品信息
PA5-55160
种属反应
宿主/亚型
分类
类型
抗原
偶联物
形式
浓度
规格
纯化类型
保存液
内含物
保存条件
运输条件
RRID
产品详细信息
Immunogen sequence: DVPDAFPELS ELSVSQLTDM NEQEEVLLEQ FLTLPQLKQI ITDKDDLVKS IEELARKNLL LEPSLEAKRQ TVLDKYELLT QMKSTF
Highest antigen sequence identity to the following orthologs: Mouse - 92%, Rat - 92%.
靶标信息
This gene belongs to the VPS37 family, and encodes a component of the ESCRT-I (endosomal sorting complex required for transport I) protein complex, required for the sorting of ubiquitinated transmembrane proteins into internal vesicles of multivesicular bodies. Expression of this gene is downregulated in hepatocellular carcinoma, and mutations in this gene are associated with autosomal recessive spastic paraplegia-53. A related pseudogene has been identified on chromosome 5. Alternatively spliced transcript variants have been found for this gene.
仅用于科研。不用于诊断过程。未经明确授权不得转售。
篇参考文献 (0)
生物信息学
蛋白别名: ESCRT-I complex subunit VPS37A; Hepatocellular carcinoma-related protein 1; hVps37A; polyglutamine binding protein 2; unnamed protein product; vacuolar protein sorting 37 homolog A; vacuolar protein sorting 37A; Vacuolar protein sorting-associated protein 37A; Vps37A; VPS37A, ESCRT-I subunit
基因别名: 2210018P21Rik; 4930592A21Rik; AW261445; D8Ertd531e; HCRP1; PQBP2; SPG53; VPS37A
UniProt ID: (Human) Q8NEZ2, (Mouse) Q8CHS8
Entrez Gene ID: (Human) 137492, (Mouse) 52348, (Rat) 290775